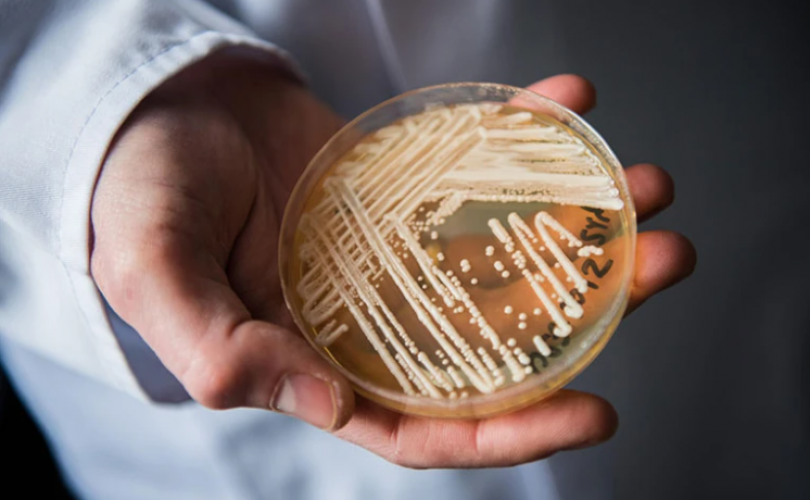
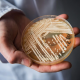

Son Dakika Bilim
İsveç Bilimler Akademisi, 2022 Nobel Kimya Ödülü’nü Carolyn Bertozzi, Morton Meldal ve Barry Sharpless’ın kazandığını açıkladı. Üç bilim insanı bu ödüle “klik kimyası” olarak bilinen ve moleküllerin birlikte kaparılmasını sağlayan çalışmalarıyla layık görüldü. Bertozzi, Meldal ve Sharpless 10 milyon İsveç kronu (yaklaşık 800 bin doları) değerindeki para ödülünü paylaşacak. Geçen yıl Nobel Kimya Öd...
Nobel Fizik Ödülü’nü kuantum mekanikleri konusundaki çalışmalarından ötürü Fransız fizikçi Alain Aspect, Amerikalı teorik ve deneysel fizikçi John F. Clauser ve Avusturyalı kuantum fizikçisi Anton Zeilinger kazandı. İsveç Kraliyet Bilimler Akademisi’nde düzenlenen basın toplantısında, ödülün, üç bilim insanına, “dolanık fotonlarla ilgili deneyler, Bell eşitsizliklerinin bozulduğu...
İki çalışma, kanser ve mantarlar arasında şimdiye kadarki en net bağlantıyı buldu. Birinde, araştırmacılar 35 kanser türünden 17.000’den fazla doku ve kan örneğinde mantar popülasyonlarını katalogladılar. Beklendiği gibi, araştırılan tüm kanser türlerinde çeşitli maya türleri de dahil olmak üzere mantarlar bulundu. Ancak bazı türler kansere bağlı olarak farklı sonuçlarla bağlantılıydı. Diğer...
Alzheimera karşı bir ilaç adayının, klinik bir denemede insanlarda bilişsel gerilemeyi %27 oranında yavaşlattığı açıklandı. Tokyo’da bir ilaç şirketi olan Eisai ve Cambridge, Massachusetts’teki biyoteknoloji firması Biogen tarafından geliştirilen lecanemab, birçok kişinin Alzheimer’ın temel nedeni olduğunu düşündüğü beyindeki amiloid-β protein kümelerini temizlemek için tasarlanm...
Araştırmacılar, Rusya’dan Almanya’ya uzanan sualtı Nord Stream gaz boru hatlarındaki gizemli sızıntıları araştırmak için acele ediyorlar. Nord Stream 2, Rusya’nın Şubat ayında Ukrayna’yı işgal etmesinden bu yana kapatıldı, ancak hala % 90 civarında metan olduğu tahmin edilen gazla dolu. Şu anda çalışmayan Nord Stream 1 boru hattında da sızıntılar olduğu bildirildi. Tahminle...
Amerikan Havacılık ve Uzay Dairesi’nin (NASA) DART misyonu çerçevesinde fırlattığı uzay aracı Dimorphos adlı asteroit ile çarpıştı. DART görevi çerçevesinde NASA, büyük asteroitlerin Dünya’ya çarpmasını engellemenin mümkün olup olmadığını belirlemeyi hedefliyor. Amerikan Havacılık ve Uzay Dairesi’nin (NASA), büyük asteroitlerin Dünya’ya çarpmasını engellemenin mümkün olup o...
NASA’nın James Webb uzay teleskobu Neptün’ün muazzam yeni fotoğraflarını çekti. 1989 yılında Voyager 2’nin Neptün’ün yanından geçerken çektiği görüntülerden bu yana ilk kez gezegen bu denli ayrıntılı bir biçimde resmedildi. Bunda uzay teleskobunun kızılötesi araçlarının kullandığı teknolojinin etkisi büyük. Fotoğraflarda buz devi olarak da bilinen Neptün’ü çevreleyen ...
Alzheimer nöronları, kanser hücrelerine çok benziyor. Tek büyük fark, kanser hücrelerinin kontrolsüz olarak çoğalmaya devam etmelerine karşın, Alzheimer sinir hücrelerinin kontrolsüz olarak ölmeleri. Innsbruck Üniversitesi’nden Jerome Mertens ve ekibi Alzheimer sinir hücrelerinin metabolizmasına odaklanarak, bunları iyi araştırılmış kanser hücresi metabolizmalarıyla karşılaştırdılar. Araştırmacıla...
Kuzey Kutbundaki sıcaklık, son bir araştırmaya göre son kırk yıl içinde, küresel ortalamanın dört katı hızlı bir şekilde arttı. Buradaki hava sıcaklığı on yılda bir 0,75 derece yükseliyor. Norveç ve Finlandiyalı araştırmacılarının şaşırtıcı sonuçları, Communications Earth & Environment dergisinde yayımlandı. Bugüne kadarki iklim modelleri çok daha yavaş bir sıcaklık artışı göstermişti. Mesela ...